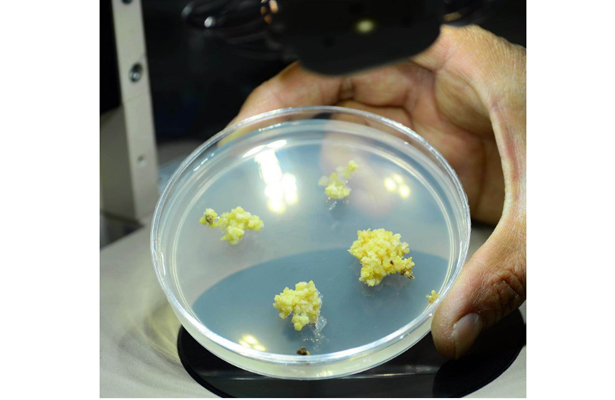

La opción de una versión oral reduciría los costos de aplicación y simplificaría ese proceso pues puede ser manejada por los propios porcicultores
Especialistas del Instituto de Investigaciones Biomédicas (IIBm) de la UNAM innovaron una vacuna para prevenir la cisticercosis porcina, a partir de la papaya (Carica papaya): en vez de ser inyectada, puede ser administrada vía oral, y ha demostrado su eficiencia en ratones y conejos.
Edda Sciutto, responsable del trabajo, recordó que desde hace varias décadas diferentes grupos de investigación de la Universidad Nacional han estudiado el complejo teniasis-cisticercosis, causado por Taenia solium, con énfasis en el desarrollo de herramientas para su diagnóstico y prevención.
Gladis Fragoso, también investigadora del IIBm, señaló que la aplicación de una vacuna inyectable implica costos logísticos a los que se agrega la dificultad de capturar a los cerdos de traspatio, que deambulan libres en las comunidades, y a los que está dirigida la vacuna.
La opción de una versión oral reduciría los costos de aplicación y simplificaría ese proceso, pues puede ser manejada por los propios porcicultores.
En el IIBm se desarrolló la vacuna contra cisticercosis compuesta por tres péptidos, denominada S3Pvac. Se generó una primer versión, producida en forma sintética, y una segunda recombinante, ambas efectivas e inyectables.
En tanto, la vacuna S3Pvac-papaya (oral) está compuesta por estos tres péptidos expresados en callos embriogénicos de papaya, añadió Marisela Hernández, coautora del trabajo.
Al respecto, Sciutto destacó que las plantas son sistemas adecuados para la expresión de vacunas orales, pues permiten la producción de antígenos vacunales sin requerir procesos de purificación adicional; además, incluyen componentes que pueden aumentar la capacidad inmunogénica.
Esta versión oral ya fue probada en condiciones experimentales, obteniendo una alta protección contra la cisticercosis, que se mantiene cuando se administra como cápsula o con diferentes alimentos. También es capaz de inducir una respuesta inmune humoral y celular administrada en cerdos.
La infección intestinal se adquiere por consumo de carne mal cocida o cruda infectada con cisticercos de Taenia solium, que pueden desarrollarse en el intestino y producir huevos microscópicos que se eliminan a través de las heces.
Si los huevos son consumidos por personas o cerdos causan cisticercosis, y si se establecen en el sistema nervioso del hombre pueden causar la forma más grave de la enfermedad: la neurocisticercosis.
Innovación tras innovación
La primera versión de la vacuna contra cisticercosis porcina: S3Pvac-sintética, fue evaluada en comunidades rurales de Puebla en condiciones naturales de transmisión, y se demostró que reducía en más del 90 por ciento. Sin embargo, resultó de alto costo para su comercialización.
Entonces se generó una nueva, expresada en forma recombinante, de mucho menor costo, denominada S3Pvac-fago, evaluada en campo en 14 comunidades de la Sierra de Huautla, Morelos. Demostró alta eficiencia, similar a la versión sintética.
S3Pvac-fago fue aplicada durante tres años en el marco de un programa de control dirigido por Aline Aluja, de la Facultad de Medicina Veterinaria y Zootecnia, mediante un proyecto financiado por la Sagarpa (Secretaría de Agricultura, Ganadería, Desarrollo Rural, Pesca y Alimentación) y el Senasica (Servicio Nacional de Sanidad, Inocuidad y Calidad Agroalimentaria).
Ahora ha sido optimizada para su uso oral, dando como resultado S3Pvac-papaya. Recientemente, investigadores de la Universidad de Guatemala manifestaron su interés por conocer el estado de la teniasis-cisticercosis en su país para desarrollar programas de control implementando el uso de la vacuna oral.
Para este propósito, un grupo de científicos de la UG se trasladó a México para acordar estrategias de trabajo y transferir la tecnología.
Foto: UNAM







